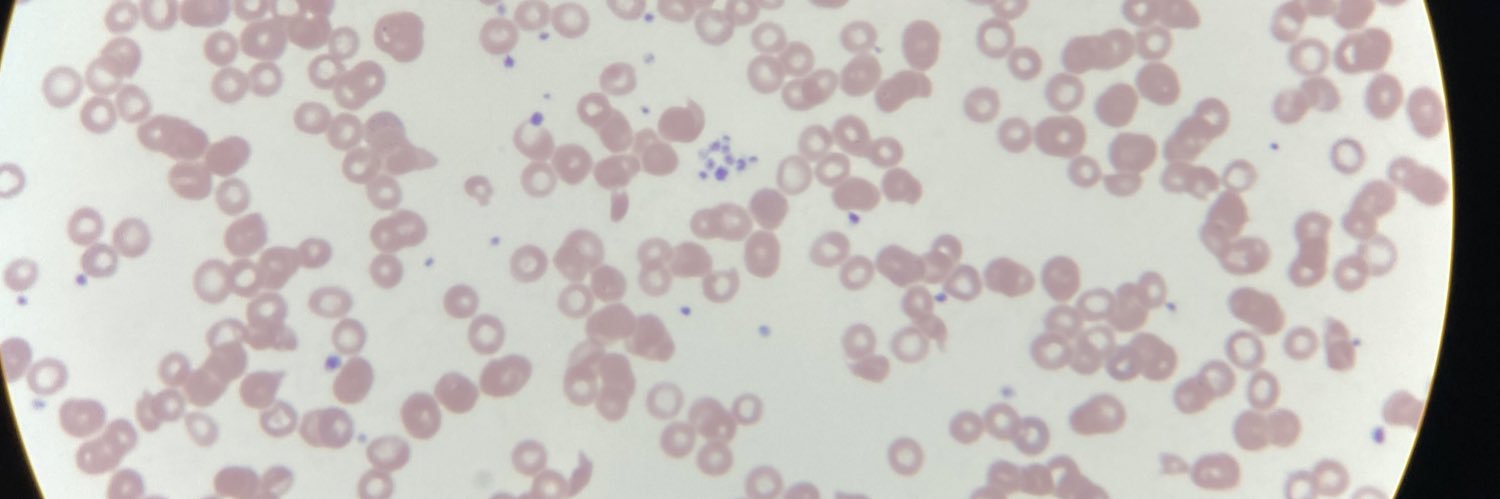
Jacob Appelbaum banner

@sanamloghavi Post your pre-print (or link once accepted)!
@sanamloghavi , wouldn’t you agree that megakaryocyte morphology is an important consideration for differentiating ET v pre-fibrotic MF? I view risks/Rx of these diseases differently. Nice example of what we should look for!
English